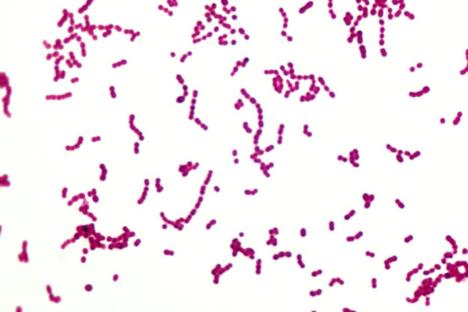
streptokoka-bakterija.jpg

GORA OD KUGE: Svetom se širi novi tip bakterije koja jede ljudsko tkivo

Novi, opasni oblik bakterije koja "jede ljudsko meso" pojavio se u Velikoj Britaniji, Japanu, Francuskoj i Švedskoj.
Ova bakterija se širi neverovatnom brzinom i može da izazove infekciju globalnih razmera. Stručnjaci kažu da već pravi velike probleme u većem delu Evrope.
Grupa bakterija tipa A streptokoke, obično izazivaju lakše infekcije, poput upale grla ili slabije infekcije kože, a lako se leči antibioticima. Međutim, u težim slučajevima, kad bakterija prodre dublje u organizam, može da izazove upalu pluća, infekciju krvi ili nekrotizirajući fasciitis, što je jedan oblik gangrene koji u najtežim slučajevima može da rezultira smrću.
Sada je pronađena nova podvrsta koja pripada ovoj grupi. Ova specifična streptokoka nazvana je "emm89".
Naučnici iz Londona su primetili da je posebna vrsta streptokoke izazvala porast infekcija između 1998. i 2009. pa su istražili o čemu se radi. Ispitali su sekvence genoma iz uzoraka koje su uzeli od pacijenata pogođenih infekcijom.

Kada su otkrili specifične sekvence bakterije "emm89", naučnici iz Kanade, Japana, Francuske i Švedske, prijavili su iste slučajeve u svojim zemljama, pa su zaključili da se ova bakterija širi globalno.
Ono po čemu se ovaj tip bakterije izdvaja od ostalih je to što ona proizvodi biše toksina i što nema spoljašnju opnu. Zbog toga je postala dominantna u odnosu na druge bakterije te vrste.
"Verovalo se da je spoljašnja opna zapravo odgovorna za invazivne bolesti kod bakterija tipa A streptokoka, pa je činjenica da su izgubile tu opnu za nas bila iznenađujuća", rekla je Kler Tarner, vođa istraživačkog tima.
Naučnici još uvek ne znaju kako bakterija uspeva da preživi bez opne, ali ono što znaju jeste da je upravo zbog toga opasnija za ljudski organizam.
"Bez kapsule ona lakše prianja za bilo koju površinu i to joj pomaže da se brže širi, a postoji mogućnost i da zbog toga lakše može da prodre u ćelije ljudskog organizma, što otežava lečenje", kaže Tarner.
Bakterija emm89 ipak reaguje na antibiotike, pa nema razloga za paniku, a naučnici se nadaju da će daljim istraživanjima uspeti da shvate zašto se tako brzo širi i time poboljšaju lečenje i zaštitu.
(Independent/Sciencealert.com)